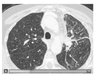

Diffuse uptake in bone marrow
MTS
Lymphoma
After chemo, GCSF
Anemia
Chronic or acute infection
Diffuse homogenous uptake in spleen
Extramedullary cell proliferation
Indirect sign of infection
Steroids
Window - first 3 days
Metformin
Diffuse uptake in small and large bowel.
Stop for 2 days before
Ipilimumab
Treat melanoma
Monoclonal antibody
High uptake in bowel because of immune-mediated toxicity
PET spatial resolution
4-5 mm - - partial volume effect
Vasculitis uptake
Homogenous diffuse uptake in vessel wall
Intense uptake in large cervical and thoracic vessels
Atherosclerosis
Focal moderate uptake at plaque with calcification
Vessels in upper abd lower limbs
Diffuse homogenous uptake in whole prosthetic valve or graft
Chronic inflammation
Focal heterogenous uptake in valve or graft
Infection
Also in locoregional LN, vegetations, abscesses, hematoma, aneurysm, fistula.
WBC on vertebral infection
Physiological uptake in bone marrow - - infection as photopenic area due to encapsulation of infection and poor migration of WBC
Parotid uptake
Warthin tumor
Pleomorphic adenoma
LN
Sarcoidosis
Pulmonary nodule uptake
Pneumonia
Tuberculosis
Cryptococcosis
Histoplasmosis
Sarcoidosis
Radiation pneumonitis
Pleurodesis
Pleural plaques
Asbestos dd epithelioid type mesothelioma
Focal hepatic uptake
MTS
Abscess
Infarct
Adrenal
Hyperplasia
Adenoma
Angiomyolipoma
Oncocytoma
Pheo
Paraganglioma
What is the critical organ for Tc-MDP?
Urinary bladder wall
Tc-MDP is used primarily for bone scans.
Tc-DTPA?
Glomerular filtration
3-5% protein binding
Also liquid aerosol for lung ventilation
Particles 1-2 microm
900-1300 MBq - - 10% in lung <100 MBq
T1/2 in lung 55-108 min
Tc-MAG3
Tubular secretion in proximal tubules
Partial glomerular filtration
80% protein binding
60% first pass
Renal + hepatobiliary excretion
Tc-Nanocolloid?
5-100 nm - - 95% <80 nm
Phagocytosis by reticuloendothelial system
Liver, Spleen, bone marrow
Tc-SC filtered
100-220 nm
Hepatosplenic scan
Bone marrow scan
Gastric emptying
Lymphoscintigraphy .
I123
T1/2 13.2 h
lower radiation burden, better image quality
159 keV
No stunning
O15-water
100% extraction rate - - high blood pool
T1/2 2 min
Range 8.2 mm
Myocardial blood flow
F-Fluripidaz
Pyridaben analog
Inhibitor of mitochondrial complex 1
Myocardial perfusion